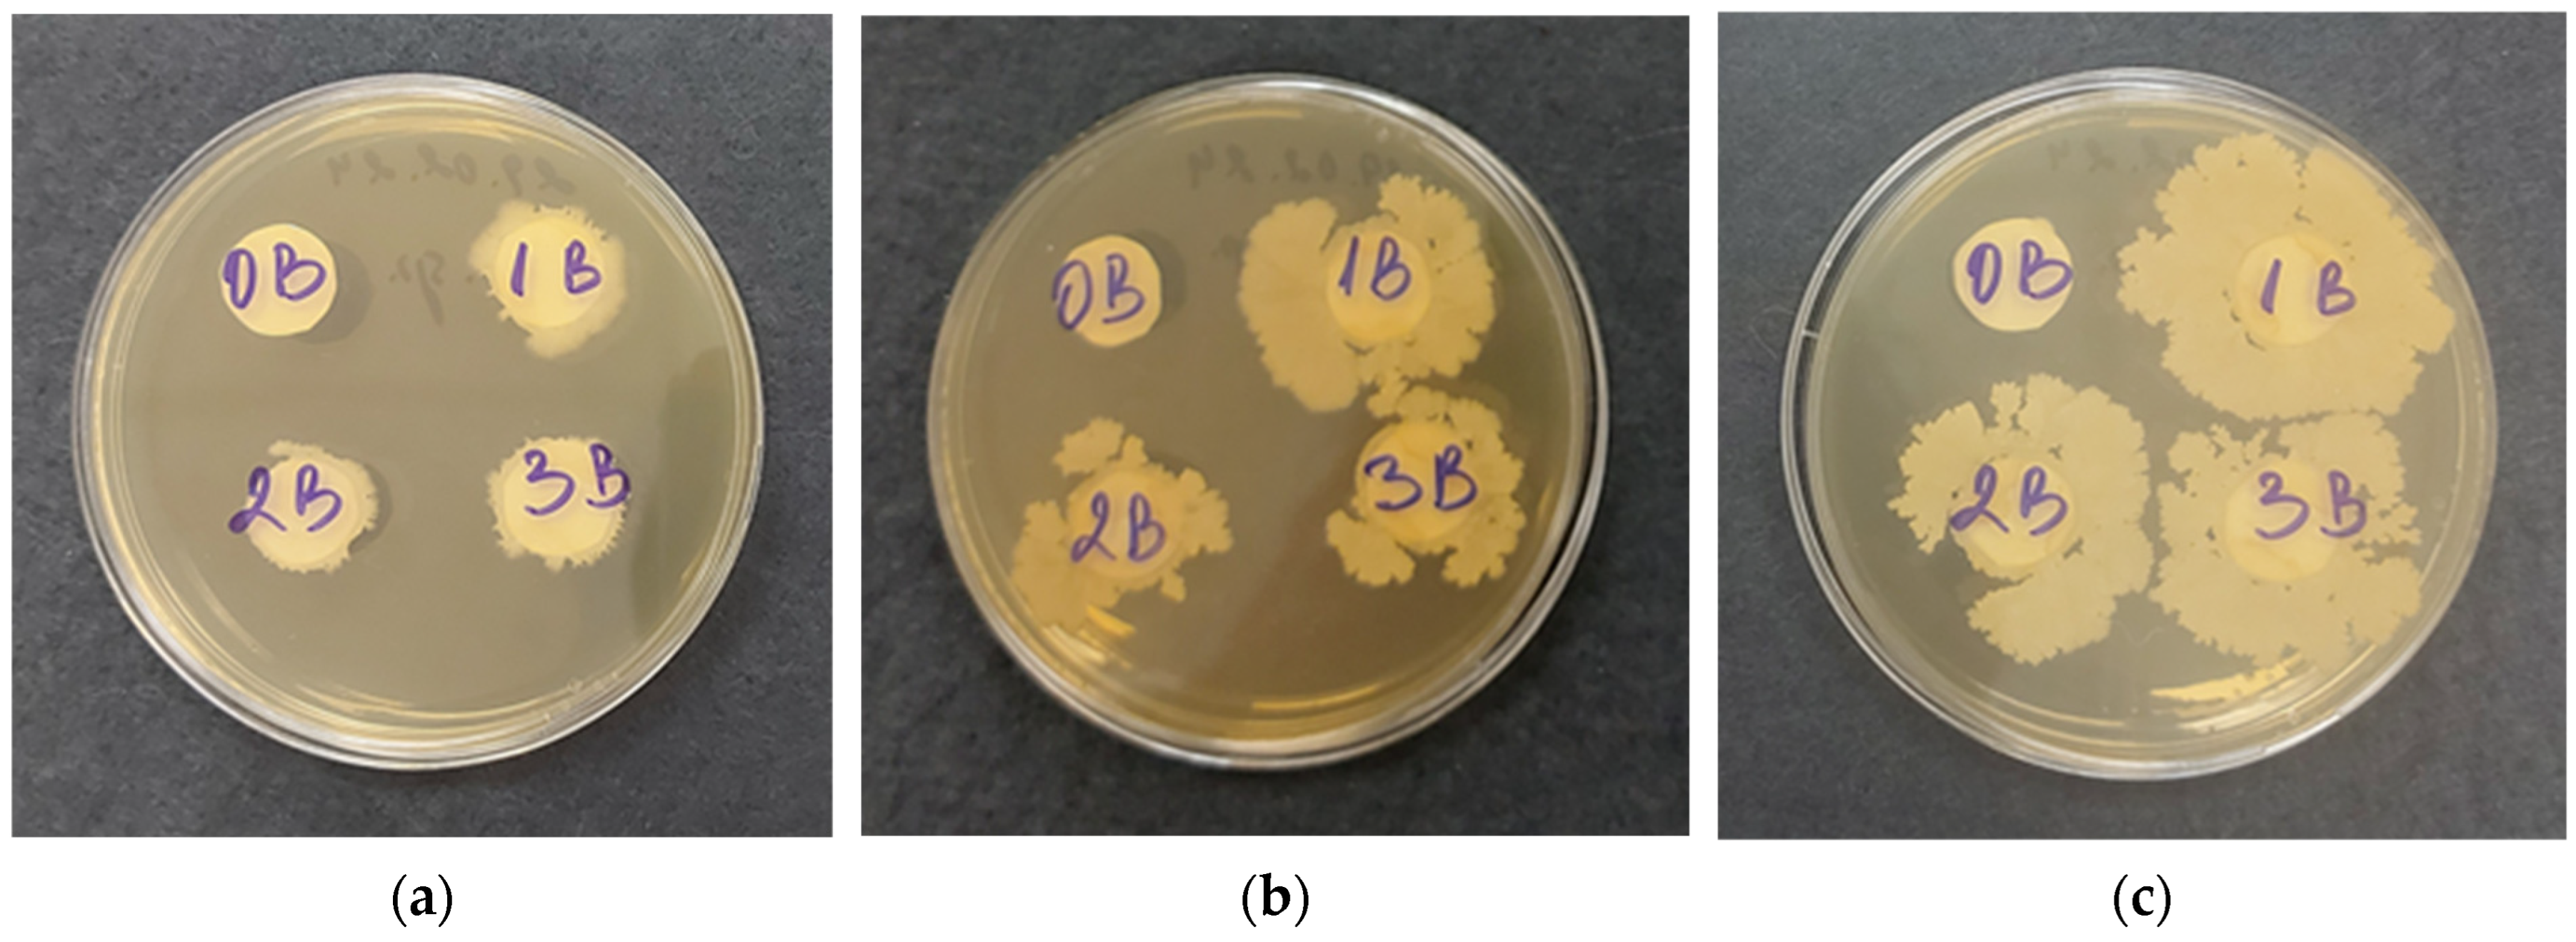
Polysaccharides 05 00044 g007
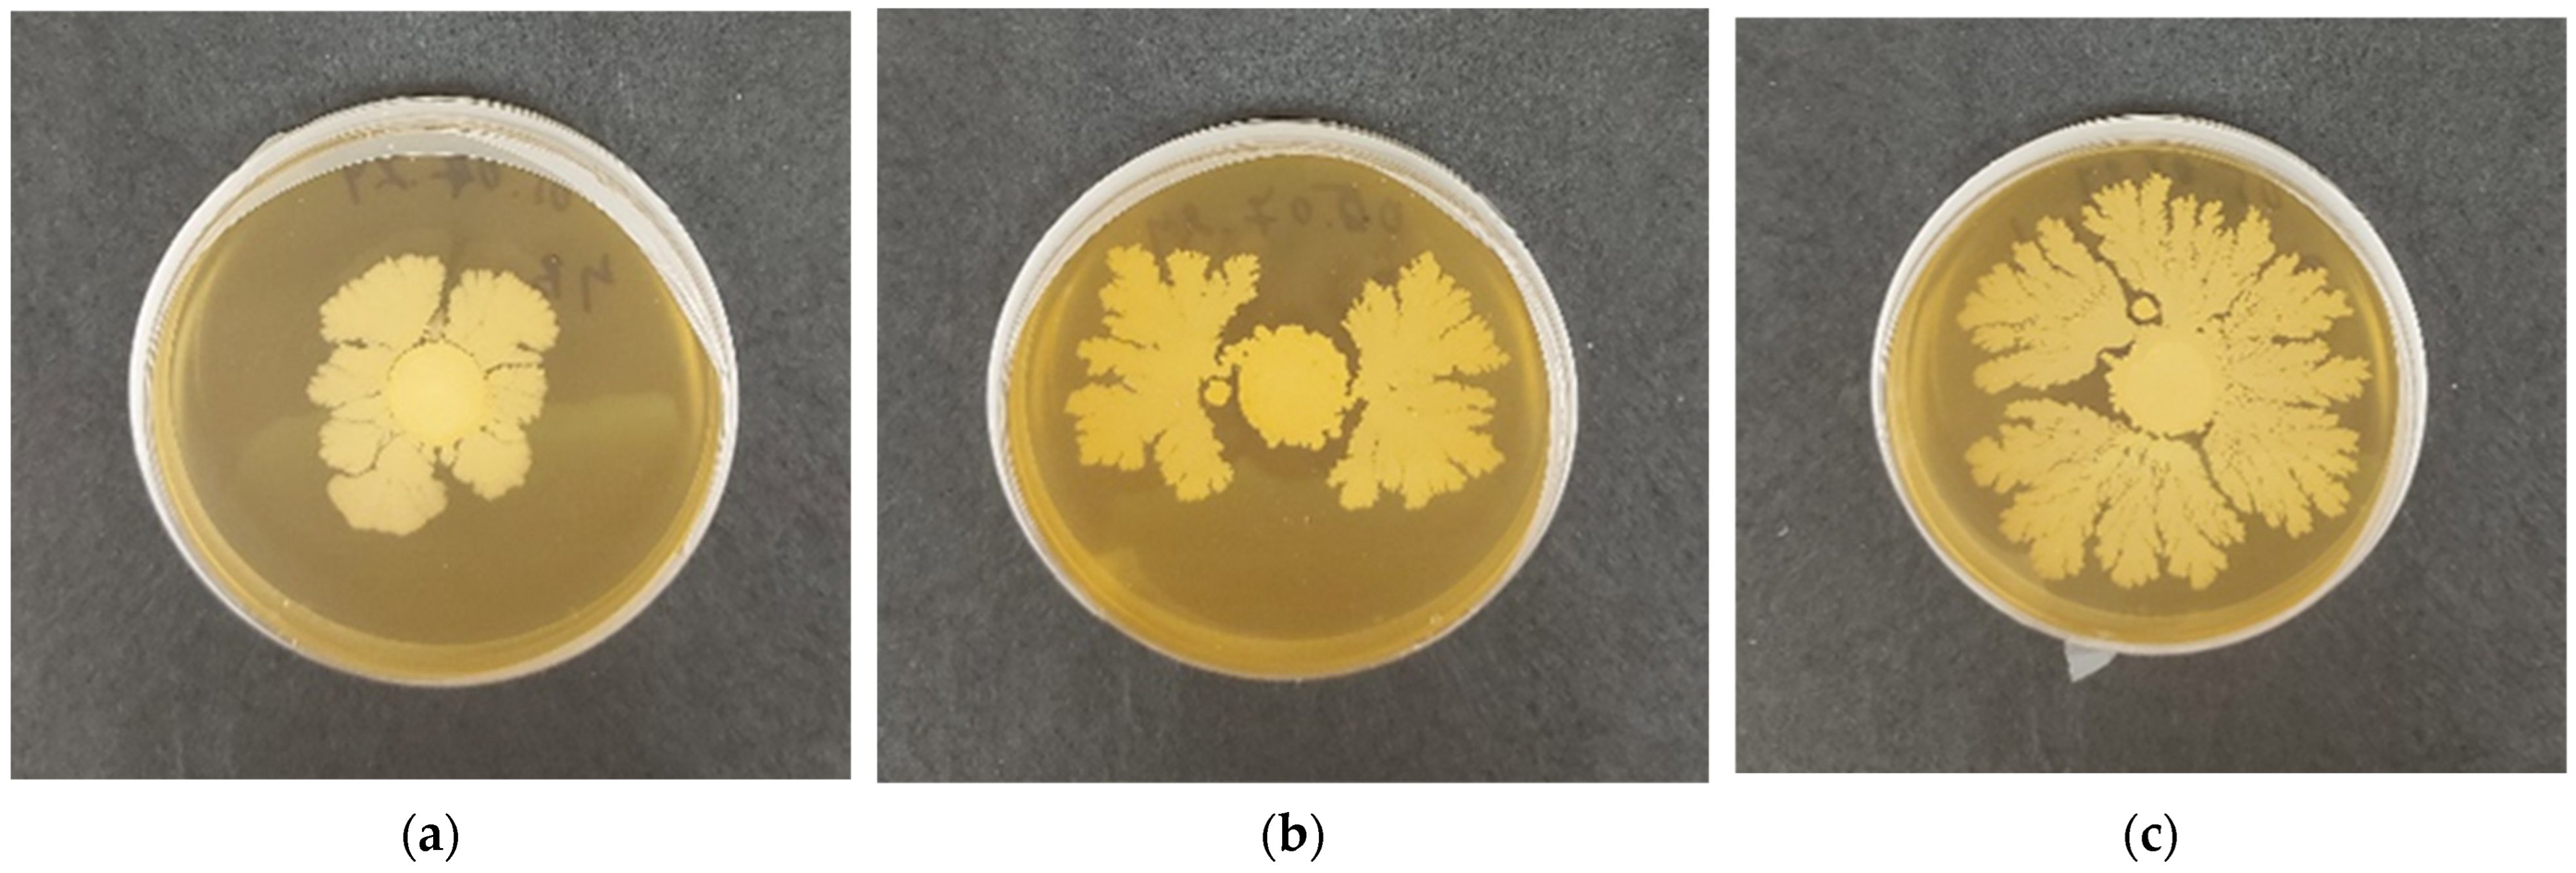
Polysaccharides 05 00044 g008
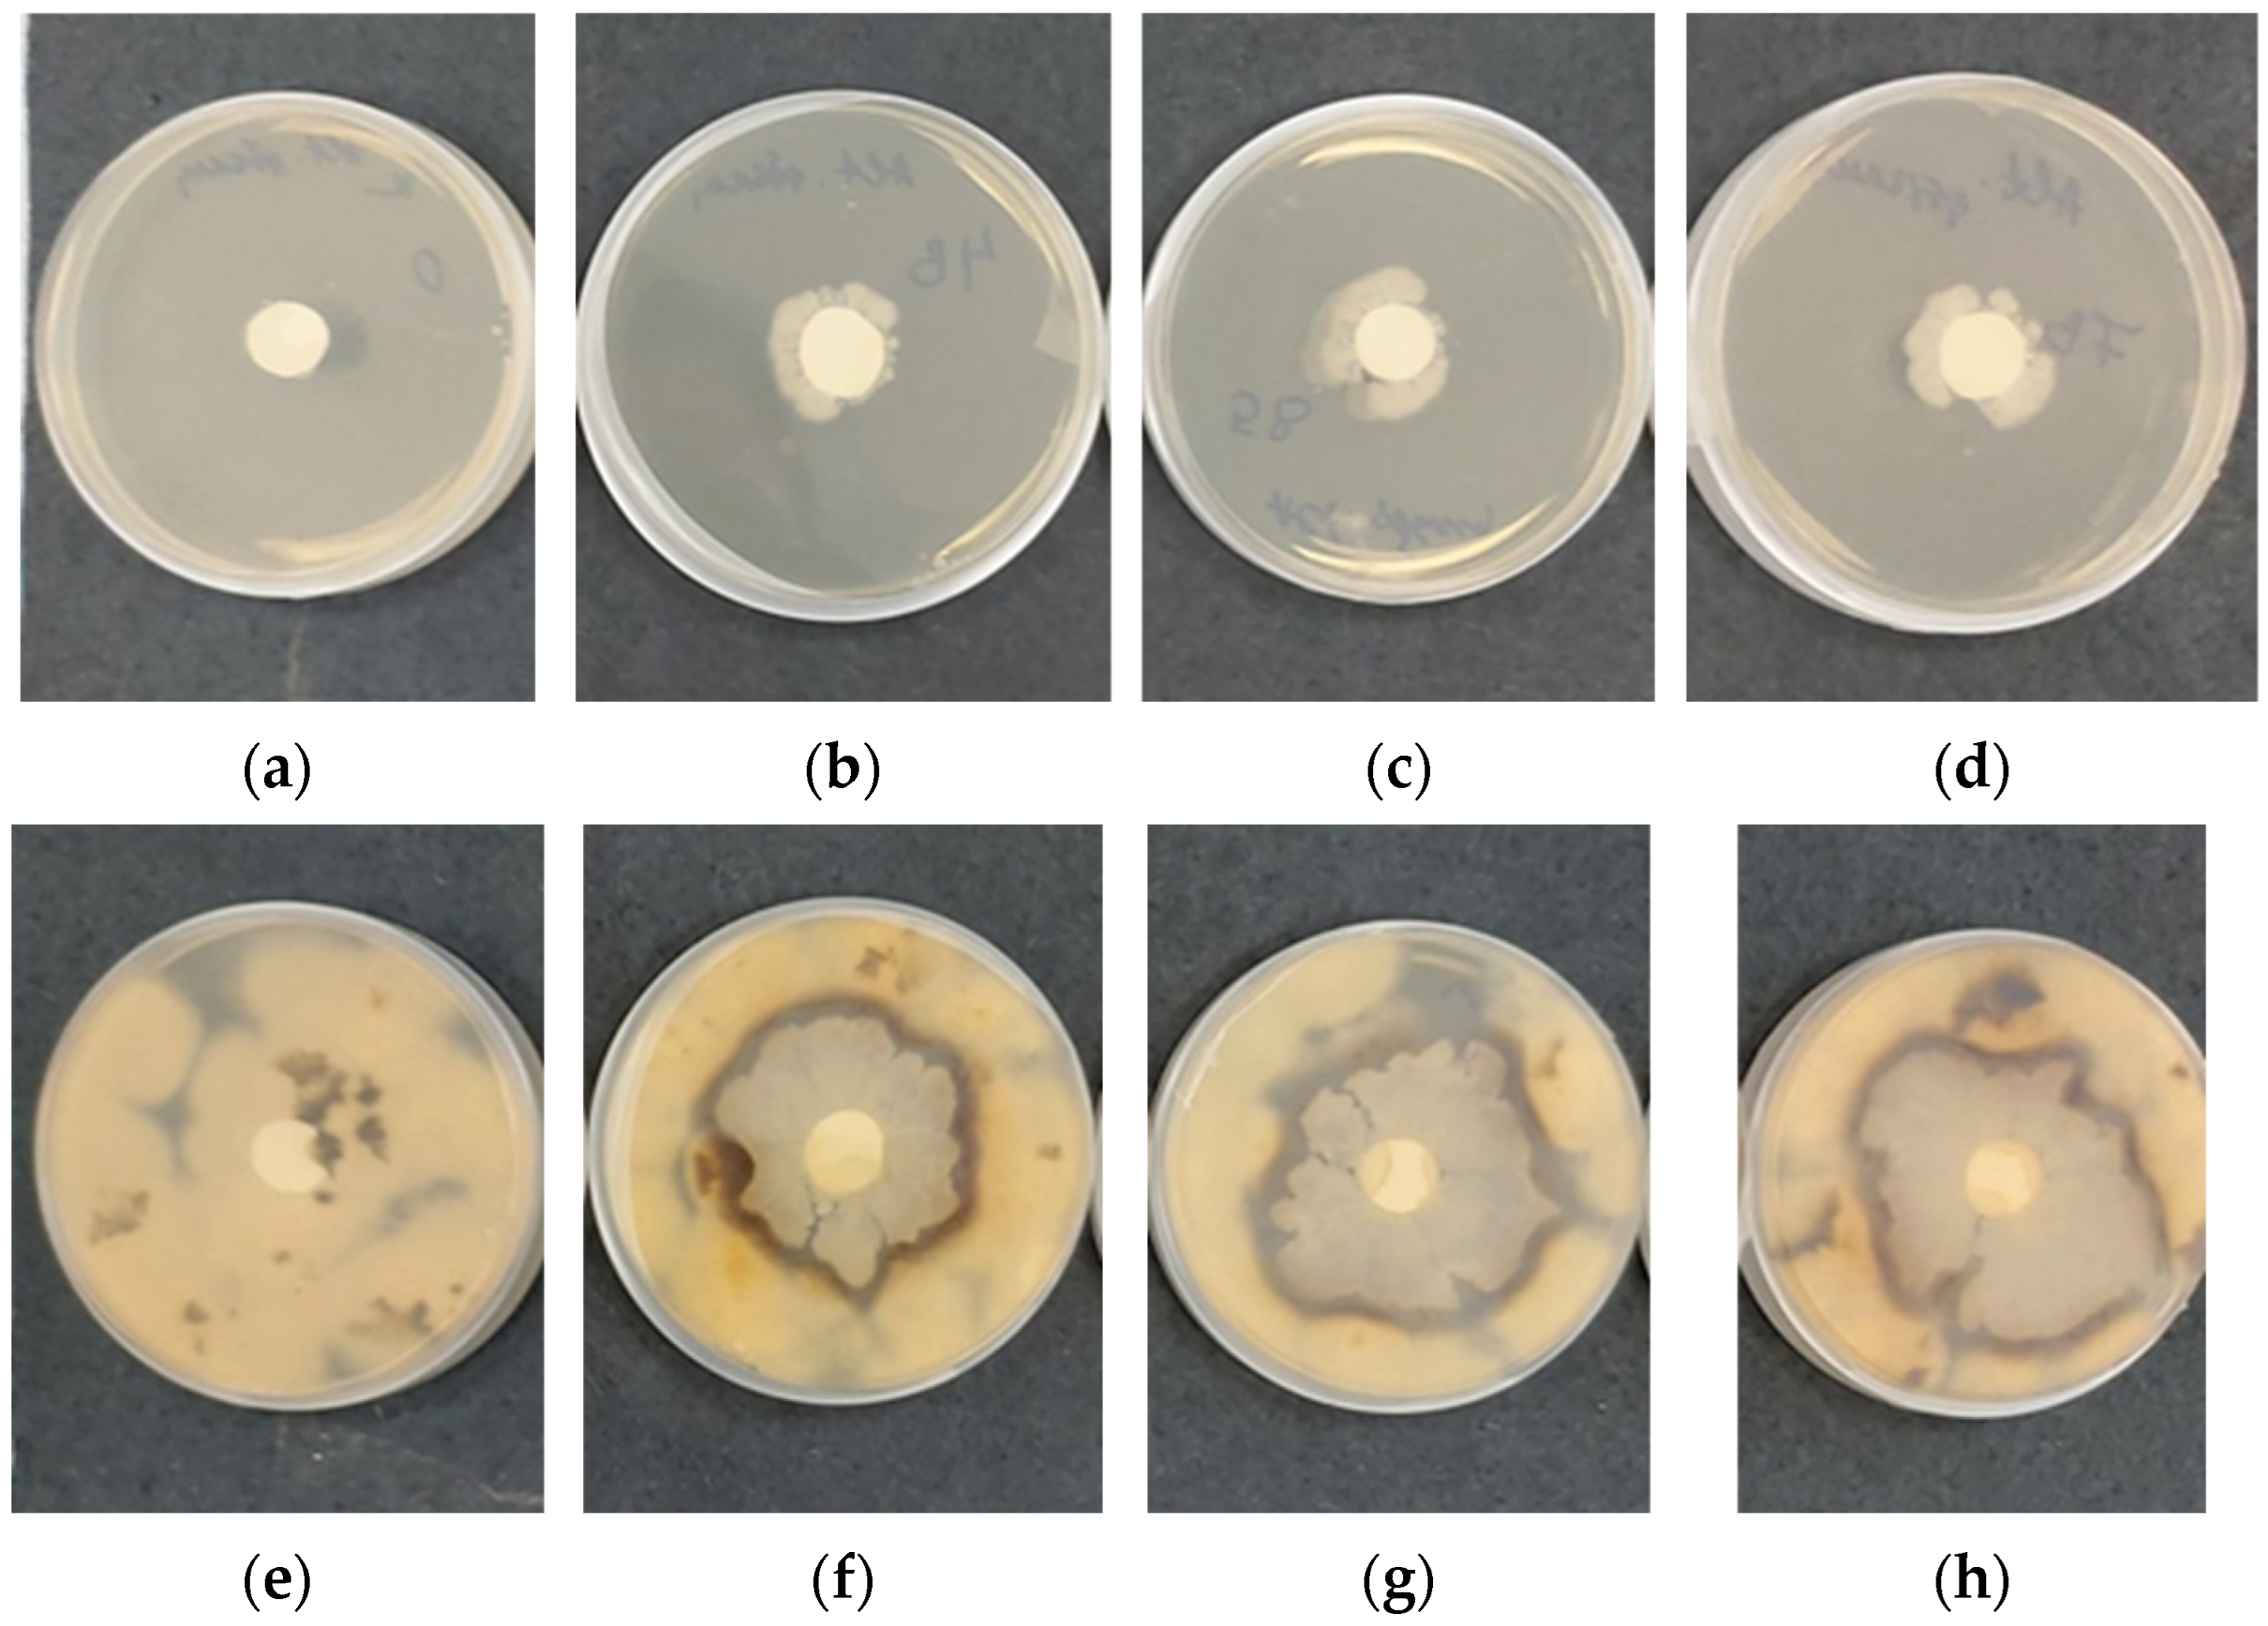
Polysaccharides 05 00044 g009

1. Introduction
Plant diseases are a major global challenge, leading to significant reductions in crop yield and quality. These diseases are caused by a wide range of pathogens, including bacteria, fungi, oomycetes, viruses, and nematodes, each targeting different plant tissues and employing diverse infection strategies. Some pathogens, like biotrophs, extract nutrients from living cells, while others, such as necrotrophs, rely on killing host cells to obtain nutrients. These pathogens may infiltrate plant tissues through intracellular or extracellular pathways, leading to widespread damage in crops [
1]. Currently, synthetic chemical pesticides serve as the primary means of plant disease control. While effective, their excessive use has raised serious environmental and health concerns, leading to contamination of soil, water, and air, as well as adverse effects on non-target organisms including beneficial insects, birds, animals, and even humans. Prolonged exposure to pesticide residues in food has been linked to the development of chronic illnesses such as neurotoxicity, cancer, respiratory disorders, reproductive health problems, and metabolic diseases like diabetes [
2]. Given these challenges, there is a growing global movement promoting the reduction in chemical pesticide use in agriculture and the implementation of more sustainable, eco-friendly agricultural practices. This shift is driven by the need to protect ecosystems, human health, and ensure food safety while maintaining agricultural productivity. Biocontrol technologies, which leverage naturally occurring organisms to suppress plant pathogens, are gaining recognition as a viable alternative to synthetic pesticides [
3]. These technologies are central to the development of safe, environmentally responsible agricultural systems, which seek to minimize chemical inputs while enhancing plant health and yield. A large-scale adoption of biocontrol strategies is critical for reducing the ecological footprint of farming practices and aligning agriculture with broader sustainability goals [
4].
One of the most promising approaches to reduce pesticide dependency is through the development of novel biocontrol agents (BCAs) and their application in crop protection. BCAs, including naturally occurring microorganisms such as yeasts, fungi, viruses, bacteria, and protozoa, are gaining attention as eco-friendly alternatives for plant disease management, because all of which can directly or indirectly inhibit plant pathogens [
5,
6]. Over the years, microbial species like
Trichoderma,
Aspergillus,
Penicillium, mycorrhizal fungi,
Bacillus, and
Pseudomonas have been formulated into commercial products with proven efficacy in controlling plant diseases [
7,
8,
9]. Among these, soil bacteria from the
Bacillus species have shown particular promise due to their ability to act against a wide range of phytopathogens, including both fungi and bacteria such as
Fusarium solani,
Pythium spp.,
Botrytis cinerea,
Sclerotinia sclerotiorum,
Rhizoctonia solani,
Ralstonia solanacearum, and
Erwinia amylovora. In addition to their pathogen-suppressing properties,
Bacillus species may also stimulate the plant’s immune system, potentially providing indirect protection against viral infections [
10]. Furthermore, biocontrol agents such as
Trichoderma and
Bacillus have demonstrated superior efficacy in controlling root and seed pathogens compared to conventional pesticides, providing safer and more sustainable crop protection options, thus reducing the need for synthetic pesticides [
10]. However, despite their advantages, the practical application of BCAs is often limited by environmental factors such as temperature, pH, and moisture, which can reduce their effectiveness in field conditions [
11]. To address these challenges, researchers are increasingly exploring the use of polymer-based carriers to encapsulate and protect beneficial microorganisms, ensuring their survival and efficacy under variable environmental conditions.
Encapsulation technology offers significant advantages for agricultural applications. By embedding microorganisms within a protective polymer matrix, encapsulation shields them from environmental stressors such as changes in moisture, temperature, and pH, thereby enhancing their viability and efficacy over time. Encapsulation also allows for the controlled release of microorganisms, reducing the need for frequent applications and improving the sustainability of biocontrol measures [
12]. A wide variety of natural and synthetic polymers, including chitosan, lignin, cellulose, alginate, and gelatin, have been used to encapsulate biocontrol agents, protecting them from abiotic and biotic stresses while maintaining their metabolic activity [
13]. These polymer carriers not only safeguard microorganisms from stress but also facilitate their controlled release, enhancing their stability and long-term effectiveness in the field, as well as provide a substrate for microbial growth, further promoting plant health and resistance to pathogens [
14].
One such polymer that has garnered attention for its biocompatibility and biodegradability is poly(3-hydroxybutyrate) (PHB), a naturally occurring biopolymer from the polyester class. Produced by a wide variety of microorganisms, PHB is an eco-friendly material with a broad range of applications, including agriculture, packaging, biomedicine, tissue engineering, and drug delivery [
15,
16,
17]. Its biodegradability makes it an attractive alternative to synthetic polymers, aligning with the global demand for sustainable materials. PHB is typically synthesized by microorganisms such as
Ralstonia eutropha,
Alcaligenes latus,
Aeromonas hydrophila,
Pseudomonas sp.,
Bacillus, and
Methylobacterium rhodesianum [
18,
19,
20,
21]. In recent years, PHB has been successfully electrospun into nanofibrous scaffolds, which are capable of supporting viable cell growth [
22,
23,
24]. These scaffolds are increasingly being explored for applications in biomedicine and agriculture due to their ability to create highly porous structures with a large surface area. Additionally, the deposition of natural polymers onto electrospun PHB fibers has been shown to enhance the mechanical and biological properties of the resulting materials, making them suitable for a variety of functional applications [
25,
26].
Among the natural polymers used for coating electrospun materials, chitosan stands out due to its remarkable biological and physicochemical properties. Chitosan is derived from the deacetylation of chitin, the second most abundant renewable polymer after cellulose. It is a linear polysaccharide consisting of β(1→4)-linked D-glucosamine and
N-acetylglucosamine units, which gives it unique properties such as biocompatibility, biodegradability, and antimicrobial activity. Chitosan is widely used in the agricultural, pharmaceutical, and biomedical fields due to its ability to form films, bind various substances, and adhere to different surfaces [
27,
28,
29,
30]. Recent advancements in chitosan processing have led to the development of chitosan oligosaccharides (COSs), which are shorter chain versions of chitosan with improved solubility across a wide range of pH levels [
31,
32]. These properties make chitosan and its derivatives ideal candidates for use as coatings in biohybrid materials aimed at protecting and delivering beneficial microorganisms.
Very recently, we showed the successful encapsulation of
Bacillus subtilis in PHB matrices coated with cellulose derivatives, demonstrating their potential in sustainable agriculture [
26]. However, the encapsulation process and the biological activity of the embedded bacteria remained a critical area for improvement. That is why the current study seeks to address this gap by exploring different coating materials, specifically focusing on the incorporation and viability of
Bacillus subtilis within PHB–chitosan matrices. The goal is to create a biohybrid system that effectively supports the growth of
B. subtilis while providing enhanced mechanical and biological properties to assess its potential as an eco-friendly solution for plant protection. To enhance the viability and functionality of the encapsulated bacteria, we focused on two key areas: first, refining the encapsulation conditions to ensure bacterial survival during electrospinning and long-term storage and second, developing a matrix that can support bacterial colonization and activity against the plant pathogen strain
Alternaria. This approach is essential for overcoming the limitations associated with the practical use of BCAs in agriculture. Due to this, here we report the fabrication of electrospun PHB matrices coated with chitosan and explore the incorporation of
Bacillus subtilis as a biocontrol agent. We also investigate how varying molecular weights of chitosan influence the mechanical properties and bacterial viability within the biohybrid system. In that way, this study could provide a robust platform for delivering biocontrol agents in eco-friendly agricultural applications, reducing the reliance on chemical pesticides, and fostering a more sustainable approach to crop protection.
2. Materials and Methods
2.1. Materials
Poly(3-hydroxybutyrate) (PHB) with an average Mw of 330,000 g/mol was supplied by Biomer (Schwalbach, Germany). Chitosan oligosaccharide (COS) with an average molecular weight of 3000–5000 g/mol was obtained from Kitto Life Co., Ltd. (Pyeongtaek-si, Gyeonggi-do, Republic of Korea). Low-molecular-weight chitosan (CS-LMW, 50,000–190,000 Da, degree of deacetylation 75–85%) and high-molecular-weight chitosan (CS-HMW, Mw ~600,000 g/mol, degree of deacetylation 80%) were both sourced from Sigma-Aldrich (St. Louis, MO, USA). Chloroform (CHCl3) and N,N-dimethylformamide (DMF) were supplied by Merck (Darmstadt, Germany). All chemicals were of analytical grade and used as received. Disposable consumables were provided by Orange Scientific (Braine-l’Alleud, Belgium).
B. subtilis was grown in liquid Tryptic Soy Broth medium (Biolife; Milan, Italy) under the following conditions: 72 h, 197 rpm, and 28 °C, until complete sporulation. The resulting biomass was harvested by centrifugation at 6000 rpm and 4 °C for 15 min, followed by two washes with sterile distilled water. The final spore concentration was determined to be 1 × 1010 spores/mL.
The pathogen used for the experiments, Alternaria sp., was pre-cultured on solid nutrient medium (PDA) for approximately three weeks until sporulation occurred. A portion of the aerial mycelium and spores was then transferred into sterile distilled water to separate the spores, which were diluted to 1 × 104. This microbial suspension was used to inoculate the surface of solid nutrient medium (PDA) in 9 cm Petri dishes.
2.2. Electrospinning of PHB
PHB spinning solution (14%
w/
v) in a mixed solvent of CHCl
3/DMF (4/1
v/
v) was electrospun to fabricate fibrous PHB materials, as previously reported [
22]. In brief, a positively charged electrode was attached to a 20 mL plastic syringe filled with the PHB solution, fitted with a 20-gauge needle. The electrode was connected to a specially designed high-voltage power source that provided a positive DC voltage in the 10–30 kV range, with a voltage of 25 kV applied during the process. The 45 mm diameter grounded rotating collector was positioned 25 cm from the needle tip, and its rotational speed was maintained at 2000 rpm. The syringe containing the PHB solution was positioned horizontally in a syringe pump (NE-300, New Era Pump Systems Inc.; Farmingdale, NY, USA), delivering the solution at a constant flow rate of 3 mL/h. The electrospinning process was carried out for a deposition time of 6 h, at an ambient temperature of 25 °C and a relative humidity of 50%. All electrospun PHB fiber materials were vacuum-dried in a heated vacuum desiccator (Vacuo-Temp, J.P. Selecta; Barcelona, Spain) at 30 °C to remove any solvent residues.
2.3. Coating of the Electrospun PHB Materials with Chitosan and Chitosan/B. subtilis
In order to study the film-forming ability on electrospun PHB materials, aqueous solutions of COS, CS-LMW, and CS-HMW at a concentration of 0.5 wt% were prepared. For the complete dissolution of CS-LMW and CS-HMW into its aqueous dispersion, glacial acetic acid was added dropwise. Additionally, a separate coating bath containing a Bacillus subtilis suspension at a concentration of 10% v/v relative to the chitosan was also prepared. In the first step of the dip-coating process, cut electrospun PHB samples (disks with diameter 16 mm) were immersed into the prepared aqueous solutions, both with and without B. subtilis, for 30 min. After immersion, the PHB mats were carefully withdrawn, blotted to remove excess liquid, and air-dried to a constant weight.
2.4. Characterization of the Prepared Fibrous Materials
The obtained fibrous PHB materials and bacteria underwent extensive morphological analysis using scanning electron microscopy (SEM). After a 60 s vacuum gold coating in a Jeol JFC-1200 fine coater, each sample was examined with a Jeol JSM-5510 (JEOL Co., Ltd., Tokyo, Japan). To determine the mean fiber diameter and standard deviation, at least thirty fibers from SEM images were quantified using the ImageJ software (v. 1.54g). Dynamic viscosities of the spinning solutions were measured using a Brookfield DV-II+ Pro viscometer (Brookfield Engineering Laboratories, Middleboro, MA, USA) fitted with a thermostatic sample cup and a cone spindle, running at 25 °C.
Attenuated total reflection Fourier-transform infrared (ATR-FTIR) spectra were recorded with an IRAffinity-1 spectrophotometer (Shimadzu Co., Kyoto, Japan) equipped with a MIRacle™ ATR accessory (diamond crystal, penetration depth of approximately 2 μm) (PIKE Technologies, Fitchburg, WI, USA). The spectra were captured at a resolution of 4 cm−1 within the 600–4000 cm−1 range. The IRsolution software (v. 1.04) was used to adjust the H2O and CO2 components of each spectrum.
The hydrophobic–hydrophilic behavior of the materials was assessed using an Easy Drop DSA20E apparatus (Krüss GmbH, Hamburg, Germany), based on surface wettability parameters. A sessile drop of deionized water (10 μL) was placed on the surface of fibrous samples (2 cm × 7 cm, cut in the direction of the collector rotation), and the average contact angle was determined through computer analysis. Each sample underwent ten measurements.
The tensile properties of the samples were assessed using a single-column INSTRON 3344 system, equipped with a 50 N load cell and Bluehill Universal software (v. 3.11). The initial length between clamps was 40 mm; the room temperature was 21 °C, and the strain rate was 10 mm/min. The specimens measured 20 mm in width, 60 mm in length, and 400 μm in thickness and were cut in the direction of the collector rotation. Ten specimens of each sample were evaluated for statistical significance, providing results for ultimate stress, maximum deformation at break, and average Young’s modulus values.
2.5. Microbiological Tests
The viability of beneficial bacteria incorporated into fibrous PHB materials was assessed by evaluating their ability to germinate and grow on a solid medium. For this purpose, Tryptic Soy Agar (TSA) was used. Disks with a diameter of 16 mm, containing samples of the various polymeric materials, were placed on the surface of sterilized TSA in Petri dishes and incubated at 28 °C. Observations of bacterial colony growth were made periodically at 18, 48, and 72 h.
Additionally, the viability of the incorporated Bacillus sp. A9.2 cells into fibrous PHB materials was assessed after 90 days of storage. Prior to the long-term storage study, the samples were kept in a desiccator at 4 °C. After 90 days, one disk was plated on solid TSA medium and incubated for 7 days at 28 °C in a thermostat.
The interaction between the beneficial bacterium Bacillus sp. A9.2, incorporated into fibrous PHB materials, and the pathogenic fungal strain Alternaria was assessed. For this, solid PDA medium was inoculated with Alternaria in 9 cm Petri dishes. A disk of the electrospun PHB biohybrid materials containing Bacillus sp. spores was placed in the center on the same Petri dish. Colony growth of both the phytopathogenic fungus and the beneficial bacteria was measured after 7 days of incubation at 28 °C.
2.6. Statistical Data Analysis
The current investigation’s results are presented as means ± standard deviation (SD). One-way analysis of variance (ANOVA) and the post hoc comparison test (Bonferroni) were used to determine the statistical significance of the data. GraphPAD Prism software, version 5 (GraphPad Software Inc., San Diego, CA, USA), was used for this study.
3. Results and Discussion
Recently, we demonstrated that enhancing the mechanical properties of electrospun materials can be achieved through the formation of a film, which improves fiber connectivity and strengthens the electrospun materials [
26,
33,
34]. While coatings of PHB with chitosan have been explored in various applications, our specific focus in this study was on developing a matrix tailored to the colonization of microbial antagonists of phytopathogens, introducing a novel and relevant perspective. Consequently, an environmentally friendly biohybrid system that serves as a carrier for
Bacillus subtilis as biocontrol formulations for crop protection was created. The combination of a degradable microbial bioplastic electrospun matrix (PHB) with a chitosan coating in this context has not been extensively explored, especially as a potential delivery system for microbial antagonists in plant protection. The use of such biohybrid systems is timely and relevant due to increasing interest in sustainable agricultural practices and the need for new-generation plant protection systems.
The first step was to produce an electrospun PHB mat, which would then be coated with a chitosan film by dipping the electrospun mats into aqueous chitosan solutions. A thin film of chitosan, ideal for incorporating beneficial microorganisms, was applied to these mats (
Scheme 1). Chitosans with different molecular weights were used to prepare the coating solutions, including chitosan oligosaccharide (COS, 3000–5000 g/mol), low-molecular-weight chitosan (CS-LMW, 50,000–190,000 Da), and high-molecular-weight chitosan (CS-HMW, ~600,000 g/mol). All chitosan solutions were in water, ensuring that the water-based solutions did not affect the desired fibrous structure of the PHB mats.
The dynamic viscosities of the prepared COS, CS-LMW, and CS-HMW solutions were measured as 37 cP, 100 cP, and 310 cP, respectively. It was observed that increasing the molecular weight of the chitosan at a constant polymer concentration of 0.5 wt% resulted in higher dynamic viscosity values. This approach aims to create biohybrid materials with superior mechanical properties that also serve as effective carriers for beneficial bacteria.
3.1. Morphological and Structural Characteristics of the Fibrous PHB Materials
Figure 1 shows the SEM micrographs of the obtained fibrous PHB materials, as well as those after immersion in chitosan solutions. It is evident that the chosen electrospinning conditions for PHB result in the formation of cylindrical and defect-free fibers (
Figure 1a). Furthermore, after immersing the fibrous PHB materials in chitosan solutions, their fibrous structure is preserved, which is a desired and expected outcome. Specifically, immersion in COS solution leads to the sticking of PHB fibers, while immersion in CS-LMW and CS-HMW solutions results not only in sticking but also in the formation of a clearly distinguishable thin film (
Figure 1b–d). It was observed that the application of the coating also affects the average diameters of the PHB fibers. The average diameter of the original PHB fibers was 120 ± 20 nm, whereas the diameters of the chitosan-coated PHB fibers were as follows: 125 ± 22 nm (COS), 130 ± 25 nm (LMW), and 135 ± 25 nm (HMW). Clearly, the molecular weight of the used chitosans influences both the viscosity of the prepared aqueous solutions and the morphology of the resulting fibrous materials, including the average diameter of the PHB fibers. It is evident that an increase in the molecular weight of the used chitosan leads to an increase in the dynamic viscosity of the coating solution and the average diameter of the resulting chitosan-coated PHB fibers. The increase in the average diameters of the PHB fibers is evidence that there is uniform coating of the individual PHB fibers with chitosan. Moreover, as the molecular weight and, consequently, the viscosity of the chitosan solutions increase, these values also increase. However, it is observed that with the increase in the molecular weight of chitosan, there are only certain areas where a thin film formed between the fibers (
Figure 1c,d). This may be due to the interactions between the electrospun PHB fibers and the chitosan coating solution, which can cause inconsistent coverage due to differences in surface energy. Variations in surface tension may lead to the chitosan solution forming beads rather than spreading uniformly, thereby affecting film-forming efficiency. Additionally, the viscosity of the chitosan solution plays a crucial role in the film-forming process and higher viscosities leading to reduced flow and spreadability. On the other hand, the formation of a thin film, in addition to coating the individual PHB fibers, is expected to have a positive impact on the mechanical properties of the materials.
ATR-FTIR spectroscopy was used to study the changes in the chemical structure of PHB fibers after being coated with chitosan.
Figure 2 presents the spectra of the original CS-HMW, the PHB fibers coated with CS-HMW, and the PHB fibers alone. In the spectrum of the original CS-HMW and the PHB fibers, the corresponding characteristic peaks are observed at 1656 cm
−1 (C=O stretching of amide I) and 1720 cm
−1, respectively, corresponding to the C=O stretching band. In addition, the spectrum of CS-HMW confirmed the presence of bands around 1417 cm
−1 and 1375 cm
−1, associated with –CH
2 bending and –CH
3 symmetrical deformations, respectively. The peak at 1279 cm
−1, linked to –CH bending in the polymer chain of PHB, was also observed. In the spectrum of the PHB mat coated with CS-HMW, characteristic bands of chitosan, in addition to the characteristic bands of PHB, were identified (
Figure 2). This confirms the successful chitosan film formation onto PHB fibers.
The degree of surface wettability is a critical factor influencing the attachment or detachment of biofilms [
34]. Therefore, measuring the surface wettability of the prepared fibrous materials is crucial, as it will come into contact with beneficial microorganisms. It is well known that PHB is a highly hydrophobic polymer, as are the fibers obtained through the electrospinning of PHB [
35]. On the other hand, it is known that the solubility of chitosan strongly depends on the pH of the medium, its degree of deacetylation, and molecular weight. While chitosan oligomers are soluble across the entire pH range, those with a high molecular weight, even with a high degree of deacetylation, are only soluble in an acidic pH. In addition, chitosan films prepared from chitosan with different molecular weights exhibit variations in their water contact angles due to differences in molecular structure and surface characteristics. Studies have shown that chitosan films with low molecular weights generally have water contact angles in the range of 70° to 90°. This range reflects the relatively smooth surface and good film-forming ability of CS-LMW, which contributes to moderate hydrophilicity. In contrast, chitosan films made from high-molecular-weight chitosan usually exhibit higher water contact angles, typically between 90° and 110°. This is attributed to the more complex surface structure and increased surface roughness of CS-HMW, which enhances hydrophobicity [
36,
37].
As expected, the molecular weight of chitosan significantly influences the water contact angle and related film properties of the chitosan-coated PHB mats. The electrospun PHB mat exhibits a hydrophobic surface with a water contact angle of approximately 98° (
Figure 3a). Coating the PHB mat with COS reduced the water contact angle to 0° (
Figure 3b), indicating that the resulting hybrid material was completely hydrophilic. The water contact angles for PHB mats coated with CS-LMW and CS-HMW were initially measured at around 69° and 75°, respectively. However, within 2 min of droplet deposition, the droplets spread and the detected water contact angles decreased to 0°. These results demonstrate that chitosan-coated PHB fibers transform the material’s wettability from highly hydrophobic, as seen in the electrospun PHB mat, to superhydrophilic in the chitosan-coated PHB mat.
3.2. Mechanical Properties of the Chitosan-Coated PHB Fibrous Materials
The conducted analyses showed that the electrospun PHB materials were successfully coated with chitosan of various molecular weights. The coating was applied by dipping the materials into aqueous solutions of the respective chitosans, thereby preserving the fibrous structure of the electrospun PHB mats. Moreover, the molecular weight of the chitosan influences both the morphology of the formed coating (ranging from fiber sticking to thin film formation) and the wettability of the resulting materials. Considering the potential applications of these materials, it was necessary to test their mechanical properties by measuring their tensile strength. The measurements were conducted in accordance with our previous measurements [
25]. The stress–strain curves are presented in
Figure 4. It is noteworthy that all chitosan-coated PHB mats exhibit improved mechanical properties compared to the uncoated PHB mat. Furthermore, coating with CS-HMW leads to a significant enhancement of the mechanical properties compared to those coated with CS-LMW or COS. This is probably due to the higher viscosity of the CS-HMW solution, which results in the formation of a thicker film on the PHB fibers and better sticking of the fibers.
From the stress–strain curves, the mechanical properties of the fibrous PHB materials before and after coating with chitosan were determined. As clearly shown by the results presented in
Figure 5, regardless of the molecular weight of the used chitosan, the chitosan-coated PHB mats exhibit better tensile strength and elastic modulus. Moreover, as the molecular weight increases, the values of these mechanical parameters increase significantly with the highest tensile strength and substantial elastic modulus observed for the electrospun CS-HMW-coated PHB mats. This was to be expected, considering the differences in the viscosities of the used chitosan solutions, as well as the film formation on the PHB fibers. The obtained results demonstrate that the approach used is a simple and effective method for enhancing the mechanical properties of electrospun polymer materials.
3.3. Morphological Characteristics of the Electrospun Chitosan-Coated PHB Biohybrid
Applying the chitosan coating to the electrospun PHB mats preserves their fibrous structure, enhances their mechanical properties, and facilitates the incorporation of various bioagents (beneficial microorganisms). Furthermore, in the next step, a coating is applied by dipping the PHB mats into an aqueous solution of chitosan, which contains beneficial microorganisms of
Bacillus subtilis (
Scheme 2). Thus, the applied chitosan coating plays an active role by ensuring the storage, transportation, and delivery of the embedded bioagent.
Bacillus subtilis is a rod-shaped bacterium extensively studied and used as a model organism for Gram-positive bacteria. Additionally, this bacterium is used as a soil inoculant in agriculture and has been identified as an effective bioproduct fungicide [
38,
39]. The
Bacillus subtilis used in this study was analyzed using SEM to determine its morphology and size.
Figure 6a displays the bacterial cells at a magnification of ×5000. From the SEM micrograph, the width and length of the rod-shaped cells were measured to be 0.736 ± 0.077 µm and 1.484 ± 0.127 µm, respectively.
Apparently, nearly the entire surface of the electrospun chitosan-coated PHB biohybrids is covered with a bacterial film, due to the encapsulated Bacillus subtilis in the chitosan films. It is evident that both the thickness of the biofilm and the number of spores is not influenced by the molecular weight of the used chitosan. All these advantages make the electrospun PHB-based biohybrids highly suitable as carriers for bioagents like Bacillus subtilis, with promising applications in eco-friendly agriculture.
3.4. Viability of the Encapsulated B. subtilis in Electrospun PHB Biohybrid Materials
The ability of the embedded
B. subtilis to develop and remain viable is a crucial factor that needs to be studied. To assess cell viability, PHB mats coated with chitosan (of varying molecular weights) and
Bacillus subtilis were placed on agar.
Figure 7 shows digital images of
B. subtilis growth after 18, 48, and 72 h of incubation. These time points were strategically chosen to capture key stages of initial bacterial growth (18 h), peak growth and biofilm formation (48 h), and material–bacteria interactions (72 h). As anticipated, no growth was observed around the uncoated PHB mat (control). Initial development of
B. subtilis was evident around the chitosan-/
B. subtilis-coated PHB mats after 18 h. Therefore, in this early growth phase, the encapsulated
B. subtilis cells remain viable and are adapting well to the biohybrid surface and the biohybrid material is facilitating nutrient diffusion. By 48 h, the growth zones expanded, and after 72 h, the growth zones merged and nearly covered the entire surface of the Petri dish. Viability at these stages undoubtedly indicates that the biohybrid materials support prolonged bacterial survival and cell adhesion, as well as bacterial survival over extended periods. Notably, all samples exhibited normal bacterial growth, but the widest growth zone was observed around the PHB mat coated with COS/
B. subtilis. This is likely because COS, with its lower molecular weight, is more easily wetted and, upon contact with moisture from the agar, creates a more favorable environment for bacterial development.
Despite the progress in developing biohybrid materials, one of the main challenges in modern eco-agriculture remains preserving the activity of the bioagents during long-term storage. As shown, B. subtilis exhibits high viability immediately after electrospinning and dip coating. However, maintaining viability during long-term storage is even more important. For that reason, the viability of B. subtilis in the electrospun PHB mats coated with chitosan of different molecular weights was tested after 90 days of storage in a desiccator at 4 °C. After this storage period, the samples were placed in Petri dishes and cultivated for 7 days at 28 °C. The bacterial growth was then assessed. Digital photographs of the Petri dishes containing the samples are shown in
Figure 8. For all samples, it is evident that B. subtilis developed normally. In addition, large growth zones were observed around the PHB mats coated with chitosan/B. subtilis of different molecular weights. This result demonstrates that after 90 days of storage, the beneficial bacteria encapsulated into the hybrid PHB materials remained alive, grew, and reproduced normally. Thus, a novel, inexpensive, and simple method for preserving microorganisms encapsulated into hybrid fibrous materials even for 90 days was developed.
3.5. Dual Culture Tests
The critical first step in the biohybrid design was to demonstrate the potential for the colonization of encapsulated B. subtilis and its suitability as a matrix for cell growth. Given that Bacillus species exhibit antifungal activity against various phytopathogens, the next step in our work was to assess the antifungal efficacy of the B. subtilis-loaded matrices against common plant pathogens.
The genus
Alternaria includes both plant pathogenic and saprophytic species that affect vegetables and crops, causing both harvest and postharvest decay of plant products, which leads to significant losses in agricultural production [
40]. For this reason, fibrous biohybrid samples were placed in Petri dishes infected with pathogenic
Alternaria fungi. Control samples of uncoated PHB mats were also included for comparison (
Figure 9a,e). After 24 h, the
Alternaria fungi had not yet started to grow (
Figure 9a–d). However, during this period,
B. subtilis began to grow from the PHB mats coated with chitosan/
B. subtilis. After 96 h, it was clear that the pathogenic fungi had colonized the entire surface of the Petri dish where the control PHB mat had been placed (
Figure 9e). In contrast,
B. subtilis continued to grow from the biohybrid samples, effectively suppressing the growth of the pathogenic fungi (
Figure 9f–h). Therefore, the beneficial microorganism encapsulated within the fibrous PHB mats remained viable and the grown
B. subtilis preserved its ability to inhibit the growth of phytopathogenic fungi from the
Alternaria genus.